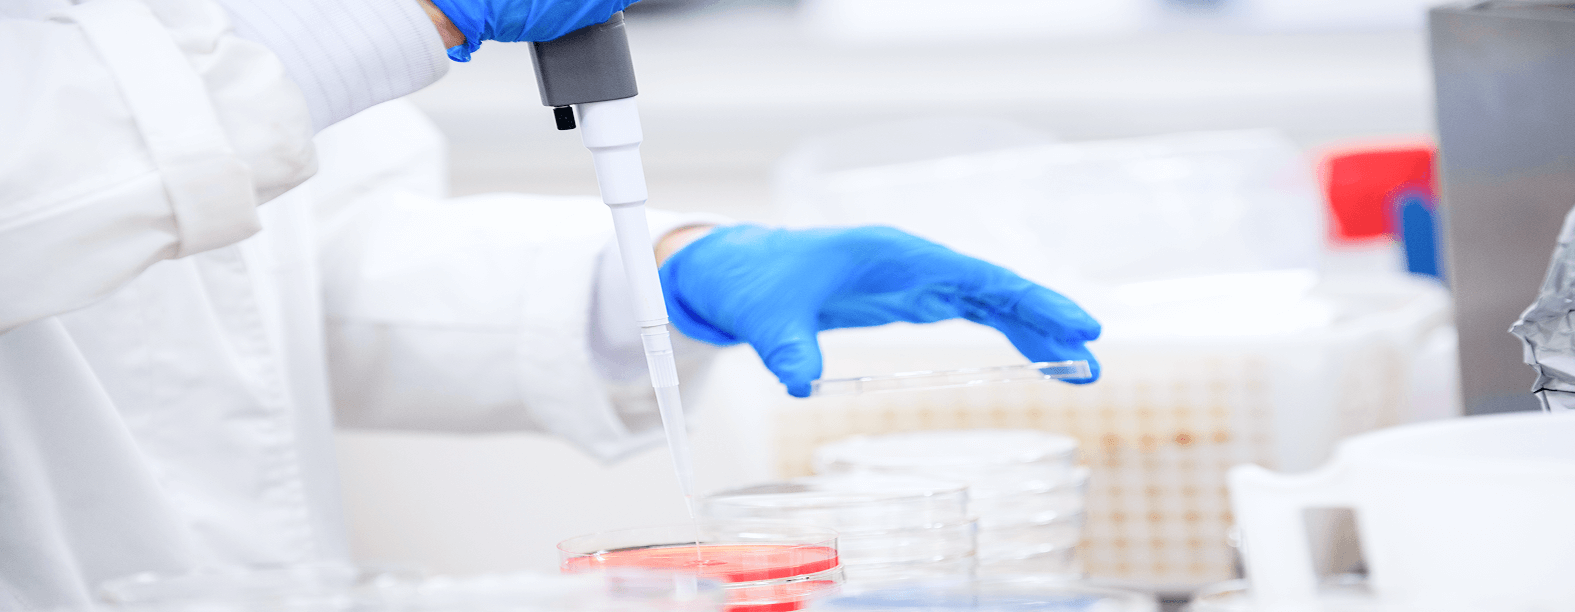
食品安全衛生管理

サンデリカでは一人ひとりの創意工夫を組織の革新に結びつけ、「食の安全」と「品質の徹底」という面でも業界のリーディングカンパニー。「食の安全」は業界の命題、当社では食品安全衛生に関する指導監視機能は、社長直轄組織としての食品衛生管理本部が担っています。
食の安全・安心に対する社会的関心が一層高まるなか、サンデリカでは「安全でおいしい商品を安定的にお届けすること」を企業の最も重要な使命と位置づけています。お客様からの信頼にお応えするため、全社員が食品安全の意識を共有し、衛生管理体制の維持・向上に努めています。また、法令や社会動向、国際的な食品安全基準の変化にも柔軟に対応し、常に時代に即した品質・衛生管理の実践を目指しています。

食の安全・安心に対する社会的関心が高まるなか、サンデリカでは、国際的な食品安全規格「FSSC22000」の認証取得を2020年より推進しています。
変化の激しい時代に対応すべく、バージョンアップされる世界の食品安全トレンドや最新の管理手法を積極的に取り入れ、より完成度の高い食品マネジメントシステムの構築に努めています。
また、現場での実践を支える取り組みとして「AIBフードセーフティ監査」を実施し、AIB国際検査統合基準に基づく品質管理体制の継続的な改善を図っています。

食品衛生管理センターは、市場買付検査、原料や製品の細菌検査、理化学検査、環境検査をはじめ、各事業所に配置した食品衛生管理センター分室員による製造ラインの衛生チェックや従業員への衛生指導を行っています。
同本部の食品衛生管理課では製品に表示する原材料、アレルゲン、添加物等の内容について食品表示法に基づき、お客様の食品選択に必要な情報の提供に努めています。

サンデリカでは、「全員参加の本物の5S」(5S:整理、整頓、清掃、清潔、躾)の取り組みを20年間継続して取り組んでおります。この改革・改善活動を通じ、全従業員一人ひとりが自ら考え、行動するという自主性、主体性を発揮することで働きがいのある仕事や職場づくりを推進しています。

サンデリカでは近年の厳しい市場の変化に対応し、お客様のニーズに素早く的確にお応えするべく、5Sを機軸とした改革・改善に取り組んでおります。当社ではこの活動をサンデリカ生産方式(Sundelica Production Way)と名づけ、「3K(危険・きつい・汚い)」「3M(ムリ・ムラ・ムダ)」の排除によって、お客様に「3A(安全・安心・安定)」な商品の提供をお約束するとともに、従業員にとって働きがいのある職場づくりを目指しております。
過去のやり方や考え方を否定し、今必要ないものを処分することで、本当に必要なものに集中すること
サンデリカにおける「整理」とは、単にいらないものを捨てることを意味するのではなく、従来の考え方や仕事の進め方そのものを見直す活動です。
過去の常識を否定し革新的な発想によって、市場の変化に柔軟に対応しています。
この「整理」のポイントは、「過去のやり方や考え方を否定し、本当に必要なものに集中すること」です。
現場では、今使わないものを持ち込まない、また必要以上の量を置かないことを徹底しています。
例えば、モノが山積みとなり現場が見通せない状態では、歩行者や運搬物との接触によるケガの危険が高まります。
見通しの良い職場環境を保つことで、3A(安全・安心・安定)の維持につなげています。
誰でもすぐに見える・分かる・できる、本質をとらえた規準やルールを設定することで、ジャストインタイムの職場にすること
サンデリカにおける「整頓」とは、単にモノをきれいに片付けることを意味するのではなく、品質基準や生産の流れなど、職場の正常な状態をルールとして明確に設定し、見えるようにする活動です。
現在さまざまなモノづくりの現場で、新人や外国人等の従業員比率増大が進んでいますが、当社では新人や外国人従業員でもすぐに見える・分かる・できる職場づくりを進めています。
一例として、資材倉庫では、写真や文字、記号を用いて保管場所が一目で分かるようにしています。
また、重たい原料は下段に配置して取り出しやすくし、必要な分だけを保管することで、誰でもすぐに分かり、すぐに取り出せる資材倉庫を実現しています。
決めた規準やルールが守られるように、守れない大もとの原因を取り除き、あらゆるムダを排除し、正常な状態を維持すること
サンデリカにおける「清掃」とは、単に掃除をすることを意味するのではなく、掃除や修理、手直しはすべてムダであると考え、そもそも汚れない、壊れない、間違えない仕組みをつくる活動です。
職場をよく観察し、あるべき姿を見据えてあらゆるムダを発見・排除することで、流れる生産工程を実現し、お客様に魅力的な品質の製品を提供しています。
私たちの職場では、常にきれいに清掃されている状態が当たり前となっています。
こうした仕組みづくりの一例として、盛付けラインでは減算式計量器を活用することで計量作業の負担を軽減し、落ち着いて規定重量を盛り付けることで、手直しの発生しない生産活動を実現しています。
整理・整頓・清掃を全員参加で実施し、維持向上することで、後退せず、永遠に進化し続けること
サンデリカにおける「清潔」とは、整理・整頓・清掃の活動を、全員参加で日々継続して実施し、維持向上していくことを指します。
全経営者・従業員からなる改善改革のための組織を編成し、目標と計画を明確にした活動を仕事の一部として進めています。
こうした活動を継続するための仕組みとして、朝礼・昼礼・終礼の「3礼」や5Sミーティングを実施しています。日々のコミュニケーションや意見交換を通じて課題を共有し、改善活動につなげることで、全従業員が参加する5S活動を推進しています。
役割と責任にふさわしい仕事ができるよう、自ら学習し、人を育成し続けることで、働きがいのある職場をつくること
どんなに素晴らしいモノづくりのしくみがあっても、それを運用できる人がいなければ意味がありません。
サンデリカではパートタイマーの方から管理職まで階層別研修・技能研修に力を入れるとともに、普段の仕事の中で人が育つ/人を育てる、従業員が達成感を感じられる職場を目指しています。
職場のルールや規律を守り、役割と責任にふさわしい仕事ができるよう、自ら学習し成長する人財の育成を進めるとともに、働きがいの向上にもつなげています。


サンデリカでは、多様化するお客様のニーズに応えるため、食材・調理方法・品質にこだわったメニュー開発を行っています。「店頭起点」の考え方のもと、生活シーンに寄り添った商品提案や専門店の味の研究を重ね、よりおいしいお弁当・おにぎり・惣菜を提供。管理栄養士監修による栄養バランスの取れた商品や地域の味を活かした開発を通じ、「安全・安心・健康」をお届けしています。
サンデリカでは、業界でも珍しい製品開発に特化した「中央研究所」を東京都墨田区両国に有しています。
製品試作室には製造現場と同等の設備を整え、新素材や新技術の研究開発を通じて、新製品の開発や高品質でおいしさを追求した魅力ある製品づくりを推進しています。さらに、施設内には検査室を備え、保存検査を迅速に行うことで、スピード感のある製品開発を実現しています。営業・生産・開発が一体となった体制のもと、新たな価値と需要の創造に挑戦するとともに、子会社・大徳食品㈱と連携した共同開発にも取り組んでいます。
全国統一製品の開発を担う「中央研究所」と、地域特性を活かした製品を開発する「事業所開発室」があり、全事業所と中央研究所を合わせた100名超の開発人財は、サンデリカの大きな強みです。営業・生産・開発が一体となったマーケティング活動を通じて、付加価値の高い、よりお客様に喜ばれる製品づくりに取り組んでいます。
また、お取引先様の店舗に来店されるお客様のニーズに合わせた製品の開発・提案を進めています。

サンデリカは、災害発生時の緊急食糧支援や、公益財団法人国際開発救援財団(FIDR)への支援を通じ、発展途上国の自立的発展に向けた援助活動を行っています。
サンデリカでは、ヤマザキグループの一員として、大規模災害の発生時に被災地への緊急食糧供給を行っています。これまで、東日本
大震災、熊本地震、能登半島地震などの際には、コンビニエンスストアや販売店への納品と並行して、緊急食糧の供給に全力で取り組
み、おにぎりやサンドイッチなどを被災地へお届けしてきました。
今後も、食生活の一端を担う企業としての使命を果たすべく、緊急食糧供給体制の整備と強化に継続して取り組んでまいります。
国際開発救援財団(FIDR)は、子どもの未来を育む「チャイルド・ケア」と「日本人と日本企業による国際協力推進」をミッションに掲げ、開発途上国の人々の自立と発展を目的として援助事業を実施している公益財団法人です。ヤマザキパンの創業者故飯島藤十郎社主が主たる基本財産を出損して平成2年に設立されました。サンデリカは、開発途上国の人々のよりよい生活の実現を願い、FIDRを支援しています。

ラブ・ローフ募金は、飢えと貧困に苦しむ世界の人々を支援するために、特定非営利活動法人ワールド・ビジョン・ジャパン(WVJ)と公益財団法人国際開発救援財団(FIDR)とが共催・実施している募金活動です。サンデリカはこの活動に協賛し、本社及び各事業所に募金箱を設置しています。これまでの募金はFIDRとWVJを通じて、アフリカなどでの国際協力活動、東日本大震災や能登半島地震、ネパール大地震およびトルコ・シリア地震の緊急援助に役立てられています。

サンデリカでは、全29事業所の各部門において業務の改革・改善活動を進めています。その一環として、持続可能な社会の実現に向け、CSR(企業の社会的責任)を果たすべく、事業活動に伴う廃棄物の発生抑制や省エネルギー対策の推進など、環境負荷軽減に継続して取り組んでいます。
当社は「もったいない」という感性で食品循環資源を無駄なく利用することが食に携わる企業の責任であると考えております。現在29事業所から年間9,000tの食品残さが排出されておりますが、その大部分(98%)を食品循環資源として、法に基づき「飼料化」最優先にリサイクルしております。

太陽光などの再生可能エネルギーを利用した発電設備を一部の工場で導入し、実効性の検証を行うとともに、従業員の意識高揚に役立てています。太陽光発電設備については、野田事業所、相模原事業所、滋賀事業所に導入しており、エネルギー使用量とCO2排出量の削減に貢献しています。